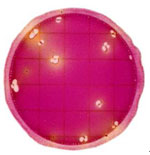

| 產(chǎn)品名稱: |
3M菌落總數(shù)測試片 |
產(chǎn)品名稱: |
3M大腸菌群測試片(1ml) |
產(chǎn)品簡述:
 |
方法:國家標(biāo)準(zhǔn)菌落總數(shù)測定法 平板計(jì)數(shù)瓊脂(PCA)培養(yǎng)基 計(jì)數(shù)所有紅點(diǎn)為菌落總數(shù) 48小時(shí)確認(rèn)菌落數(shù) 亦適用于乳酸菌檢測 SN行業(yè)標(biāo)準(zhǔn): SN/T1897-2007(菌落總數(shù)) SN/T1941.2-2007(乳酸菌) AOAC官方標(biāo)準(zhǔn):OMA990.12 型號:6406 規(guī)格:50片/包,20包/箱 |
產(chǎn)品簡述:
 |
方法:國家標(biāo)準(zhǔn)大腸菌群平板計(jì)數(shù)法 結(jié)晶紫中性紅膽鹽瓊脂(VRBA) 接種量為1ml 計(jì)數(shù)所有帶氣泡的紅點(diǎn)為大腸菌群 24小時(shí)即可確認(rèn)菌落數(shù),節(jié)省檢驗(yàn)時(shí)間2天 SN行業(yè)標(biāo)準(zhǔn): SN/T1896-2007 AOAC官方標(biāo)準(zhǔn):OMA991.14 型號:6416 規(guī)格:25片/包,40包/箱 |
| 產(chǎn)品名稱: |
3M大腸菌群/大腸桿菌測試片 |
產(chǎn)品名稱: |
3M大腸菌群測試片(5ml) |
產(chǎn)品簡述:
 |
結(jié)晶紫中性紅膽鹽瓊脂(VRBA) 同時(shí)檢測大腸桿菌和大腸菌群 計(jì)數(shù)所有帶氣泡的藍(lán)點(diǎn)為大腸桿菌 計(jì)數(shù)所有帶氣泡的紅點(diǎn)和藍(lán)點(diǎn)為大腸菌群 24-48小時(shí)確認(rèn)大腸桿菌結(jié)果,節(jié)省時(shí)間2-3天 肉,家禽與海產(chǎn)品,24小時(shí)可確認(rèn)大腸桿菌結(jié)果 其它食品,48小時(shí)確認(rèn)大腸桿菌結(jié)果 SN行業(yè)標(biāo)準(zhǔn): SN/T1896-2007 AOAC官方標(biāo)準(zhǔn):OMA991.14 型號:6414 規(guī)格:25片/包,20包/箱 |
產(chǎn)品簡述:
 |
方法:國家標(biāo)準(zhǔn)大腸菌群平板計(jì)數(shù)法 結(jié)晶紫中性紅膽鹽瓊脂(VRBA) 接種量為5ml 計(jì)數(shù)所有帶氣泡的紅點(diǎn)為大腸菌群 24小時(shí)即可確認(rèn)菌落數(shù),節(jié)省檢驗(yàn)時(shí)間2天 SN行業(yè)標(biāo)準(zhǔn): SN/T1896-2007 AOAC官方標(biāo)準(zhǔn):OMA991.14 型號:6416 規(guī)格:25片/包,20包/箱 |
| 產(chǎn)品名稱: |
3M霉菌和酵母菌測試片 |
產(chǎn)品名稱: |
3M金黃色葡萄球菌測試片及確認(rèn)反應(yīng)片 |
產(chǎn)品簡述:
 |
可同時(shí)生長霉菌與酵母,細(xì)菌無法生長 通過菌落形態(tài)可分別計(jì)數(shù)霉菌與酵母 3-5天確認(rèn)結(jié)果 AOAC官方標(biāo)準(zhǔn):OMA997.02 型號:6417 規(guī)格:50片/包,20包/箱 |
產(chǎn)品簡述:
 |
方法:國家標(biāo)準(zhǔn)金黃色葡萄球菌Baird-parker平板計(jì)數(shù)法 Baird-parker瓊脂平板 計(jì)數(shù)所有紫紅色點(diǎn)為金黃色葡萄球菌 確認(rèn)反應(yīng)片幫助確認(rèn)紫紅色點(diǎn)以外的菌落(粉紅色暈圈) 22-29小時(shí)內(nèi)確認(rèn)結(jié)果 確認(rèn)反應(yīng)片并非必須 SN行業(yè)標(biāo)準(zhǔn): SN/T1895-2007 AOAC官方標(biāo)準(zhǔn):OMA2003.07,2003.08,2003.11 型號:6491(金黃色葡萄球菌測試片) 規(guī)格:25片/包,20包/箱 型號:6493(確認(rèn)反應(yīng)片) 規(guī)格:20片/包,5包/箱 |
| 產(chǎn)品名稱: |
3M大腸菌群測試片(快速型) |
產(chǎn)品名稱: |
3M腸桿菌科測試片 |
產(chǎn)品簡述:
 |
方法:國家標(biāo)準(zhǔn)大腸菌群平板計(jì)數(shù)法 結(jié)晶紫中性紅膽鹽瓊脂(VRBA) 計(jì)數(shù)所有帶氣泡的紅點(diǎn)為大腸菌群 6-14小時(shí)培養(yǎng)可估計(jì)大腸菌群數(shù)(黃色斑點(diǎn)) AOAC官方標(biāo)準(zhǔn):OMA2000.15 型號:6412 規(guī)格:25片/包,20包/箱
|
產(chǎn)品簡述:
|
結(jié)晶紫中性紅膽鹽瓊脂(VRBA) 計(jì)數(shù)所有帶氣泡,帶黃暈或兩者皆有的紅點(diǎn)為腸桿菌科菌落 24小時(shí)確認(rèn)結(jié)果 腸桿菌科包含大腸菌群、沙門氏菌、志賀氏菌和耶爾森氏菌等 AOAC官方標(biāo)準(zhǔn):OMA2003.01 型號:6421 規(guī)格:25片/包,40包/箱
|
| 產(chǎn)品名稱: |
3M環(huán)境李斯特菌測試片 |
產(chǎn)品名稱: |
3M電子移液器 |
產(chǎn)品簡述:
 |
適用于環(huán)境中李斯特菌屬的監(jiān)測 無需增菌 計(jì)數(shù)所有紫紅點(diǎn)為李斯特菌菌落 28±2小時(shí)確認(rèn)結(jié)果 AOAC官方標(biāo)準(zhǔn):RI030601 型號:6448 規(guī)格:25片/包,8包/箱 |
產(chǎn)品簡述:
 |
可預(yù)設(shè)多種稀釋程序 準(zhǔn)確調(diào)節(jié)移液速度 通用的槍頭 配充電支架–放置、充電 自動(dòng)檢測校準(zhǔn)誤差滿足FDA2400規(guī)程 型號: 6502(0.05-1.00mL) 6503(0.10-5.00mL) 規(guī)格:1套 |
| 產(chǎn)品名稱: |
3M Quick Swab快速涂抹棒 |
產(chǎn)品名稱: |
3M Swab涂抹棒 |
產(chǎn)品簡述:
 |
外殼為塑料材質(zhì),符合HACCP要求 內(nèi)含1ml Letheen肉湯,能中和環(huán)境中的消毒劑 人造纖維涂抹頭,相比棉頭微生物釋放率顯著提高 型號:6433 規(guī)格:25支/包,10包/箱 |
產(chǎn)品簡述:
 |
帶1ml刻度的滴管設(shè)計(jì),方便定量移液 內(nèi)含10ml緩沖蛋白胨水,對受損微生物有修復(fù)作用 人造纖維涂抹頭,相比棉頭微生物釋放率顯著提高 型號:6437 規(guī)格:10支/盒,40盒/箱 |
| 產(chǎn)品名稱: |
3M Sponge-Stick海綿涂抹棒 |
產(chǎn)品名稱: |
3M HYDRA-SPONGE涂抹海綿 |
產(chǎn)品簡述:
 |
配置手柄方便無菌采樣 4cm*7.5cm涂抹頭適合大面積采樣(如致病菌環(huán)境采樣) 10ml中和緩沖液預(yù)潤濕 不含抑菌成份的纖維素海綿頭 樣品袋材質(zhì)牢固,防漏 型號:SSL10NB 規(guī)格:100個(gè)/箱 |
產(chǎn)品簡述:
 |
附無菌手套,方便無菌采樣 4cm*7.5cm涂抹頭適合大面積采樣(如致病菌環(huán)境采樣) 10ml中和緩沖預(yù)潤濕 不含抑菌成份的纖維素海綿頭 樣品袋材質(zhì)牢固,防漏 型號:HS10NB2G 規(guī)格:100個(gè)/箱 |
| 3M取樣袋 |
堅(jiān)固的多層膜材質(zhì),防破損 金屬封口,方便開合 型號:BP114S(120ml,4oz) BP115S(540ml,18oz) BP127S(710ml,24oz) BP701(1620ml,55oz) 規(guī)格:1000個(gè)/箱 型號: BP1015(3460ml,117oz) BP41212(5L,167oz) BP41218(10.8L,367oz) 規(guī)格:250個(gè)/箱 |
3M均質(zhì)袋 |
堅(jiān)固的多層膜材質(zhì),防破損 4mm寬的熱封,充分防止漏液 18cmX30cm 內(nèi)含過濾網(wǎng),去降雜質(zhì)干擾(含濾網(wǎng)型) 型號:BP913S(普通) 規(guī)格:1000個(gè)/箱 型號:BP914S(含小孔徑濾網(wǎng)) 規(guī)格:400個(gè)/箱 型號:6469(含大孔徑濾網(wǎng)) |
 |
 |
| 3M Fip-Top無菌稀釋瓶 |
瓶蓋方便單手開啟 內(nèi)含9ml或90ml的無菌磷酸緩沖稀釋液 瓶蓋與瓶身連接,可保持開啟狀態(tài),方便移液操作 型號:BPPFV9BFD(9ml) 規(guī)格:100瓶/箱 型號:FTBFD90(90ml) 規(guī)格:66瓶/箱 |
3M Dilution Pouch無菌稀釋袋 |
獨(dú)立無菌包裝 內(nèi)含225ml無菌磷酸緩沖稀釋液,符合國家標(biāo)準(zhǔn)要求 直接加樣均質(zhì) 型號:QDBFD225 規(guī)格:32個(gè)/箱 |
 |
 |
一次性均質(zhì)袋
|
各種規(guī)格均質(zhì)袋:80ml、400ml、3500ml等規(guī)格; 聚乙烯/尼龍外壁能有效消除在均質(zhì)混合過程中袋子被刺破的可能性; 有帶過濾膜的均質(zhì)袋可選; 規(guī)格:250個(gè)/袋,1000個(gè)/箱 |
均質(zhì)袋樣品架
|
均質(zhì)袋架可用于混合前的樣品分批準(zhǔn)備和混合后的樣品儲(chǔ)存。 不銹鋼制作; 最多能放10個(gè)400ml系列的均質(zhì)袋; 適用于大部分恒溫箱; 可用于高壓滅菌
|
 |
 |
| 均質(zhì)袋夾子 |
此產(chǎn)品可與均質(zhì)袋樣品架一起使用,也可單獨(dú)使用,用于臨時(shí)密封均質(zhì)袋并儲(chǔ)存樣品; 各種規(guī)格可選(如:80、400、3500系列); 規(guī)格:10個(gè)一包 |
表面過敏原快速檢測棒
|
用于檢測8種常見的過敏原(牛乳、雞蛋、小麥、花生、大豆、堅(jiān)果、魚和貝殼類); 10-15分鐘內(nèi)得到檢測結(jié)果; 對照比色卡的半定量檢測方法 靈敏度:50ug或3ug蛋白殘留 規(guī)格:50支/盒 室溫保存、無需冷藏 |
 |
 |
滅菌指示膠袋(包外)
|
用于各種下排氣、預(yù)真空鍋,指示滅菌包是否滅菌,并判讀包外滅菌效果; 膠帶上有不規(guī)則斷續(xù)的斜形指示劑,只有在一定溫度、壓力的飽和蒸汽作用下,經(jīng)一定時(shí)間后,才能變成深褐色; 用圓珠筆及標(biāo)記筆,在膠帶上可作相關(guān)記錄; 可用于封包,保證滅菌包裹既不緊也不松; 規(guī)格:1222 1.9cm X 55 m, 48卷/箱 1222S 1.9cm X 30 m, 20卷/箱 |
指示膠貼(包外) |
為用戶著想的獨(dú)到標(biāo)帖式設(shè)計(jì)更有利于標(biāo)準(zhǔn)化管理 |
 |
 |
| 指示膠貼(包內(nèi)) |
專用于壓力蒸汽滅菌,鑒定每一個(gè)包裹內(nèi)部的滅菌質(zhì)量
|
滅菌指標(biāo)劑 |
壓力蒸汽采用嗜熱脂肪桿菌芽胞ATCC7953 獨(dú)創(chuàng)自含式設(shè)計(jì);防止二次污染; 標(biāo)準(zhǔn)型 24小時(shí)開始閱讀,48小時(shí)判讀結(jié)果 快速型,只需3小時(shí),即可判讀結(jié)果。 標(biāo)準(zhǔn)測試包根據(jù)美國AAMI標(biāo)準(zhǔn)設(shè)計(jì),精確,方便
|
 |
 |